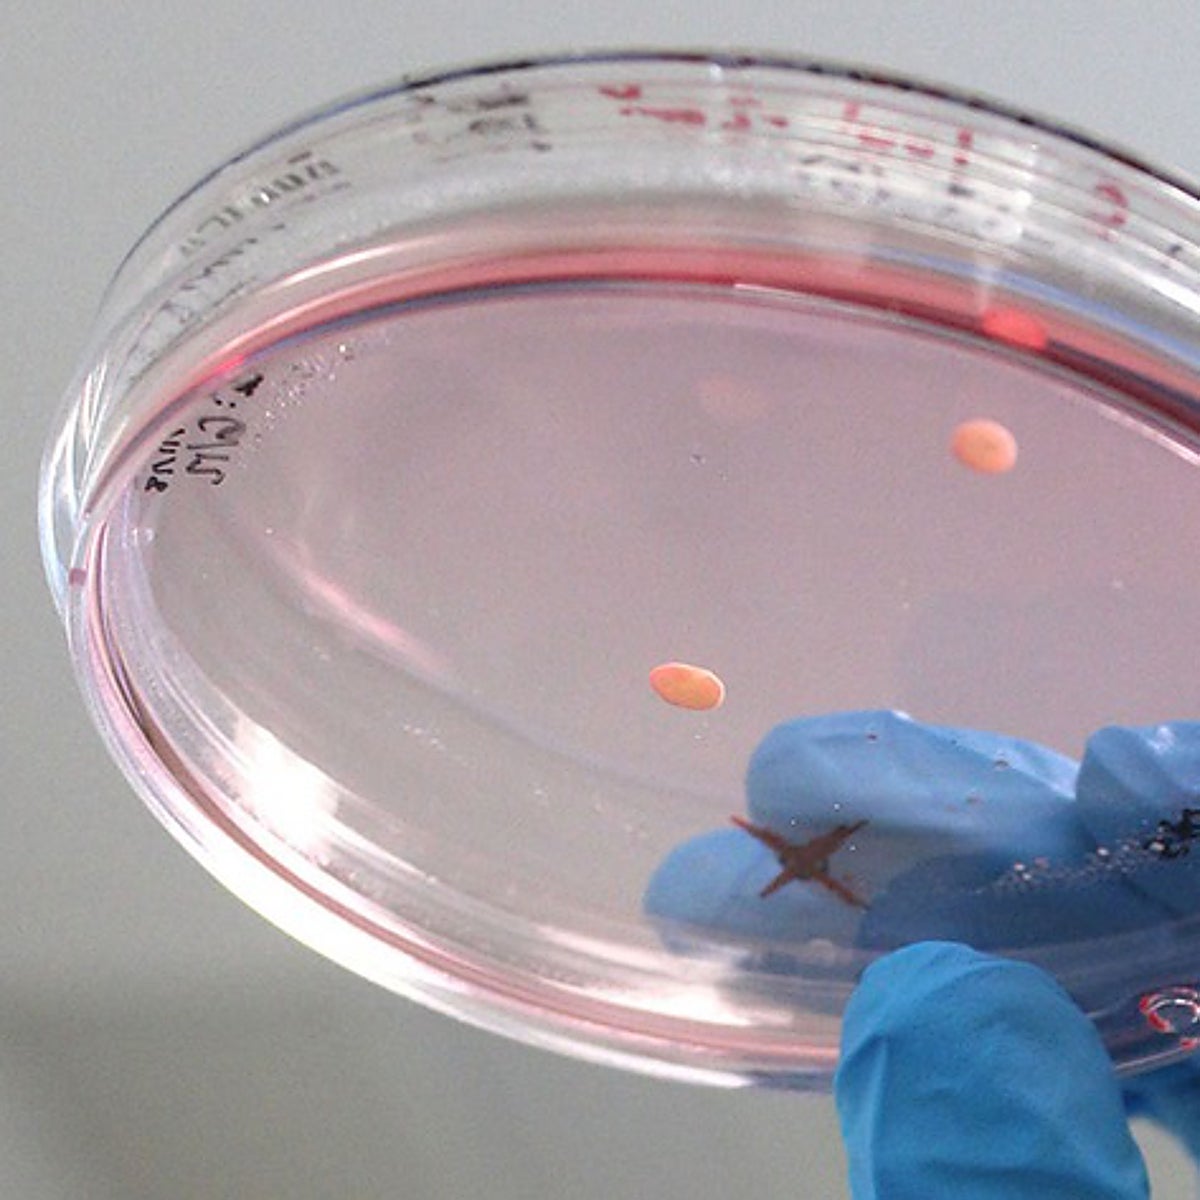
Organoides cultivados en laboratorio revelan información sobre el autismo

¿Fin de la calvicie?: Primer paso para cultivar en el laboratorio una fuente inagotable de pelo
Por primera vez se ha conseguido fabricar folículos pilosos maduros de ratón que puede revolucionar el tratamiento de la alopecia
Si se confirman los resultados, ya no será necesario extirpar el cabello de una zona para reimplantarlo, bastará con hacerlo crecer in vitro


Madrid
Esta funcionalidad es sólo para registrados
Iniciar sesiónCientíficos de la Universidad Yokohama, en Japón, han dado un paso clave para obtener en el laboratorio una fuente inagotable de cabello, listo para trasplantar. Por primera vez se han obtenido folículos pilosos maduros 'in vitro', un avance que despejaría uno de los principales ... problemas de los injertos de pelo: contar con cabello abundante y el suficiente grosor y calidad para repoblar las cabezas más despejadas. Sin una buena zona donante de donde extraer, pelo a pelo, el cabello que se va a injertar, también uno a uno, el trasplante capilar fracasa.
Los investigadores de la universidad japonesa han demostrado que ese es un problema fácil de sortear con la fabricación 'in vitro' de folículos pilosos a partir de células de la piel de ratones, según detallan en la revista Science Advances. Para ello, cultivaron las células en un tipo especial de gel que permitió reprogramar las células y crear los folículos, es decir el cabello en su totalidad. Los folículos pilosos crecieron durante un mes, alcanzando hasta 3 milímetros de largo de pelo de roedor.
Aunque se ha conseguido solo en ratones, los investigadores nipones confían en reproducir el mismo resultado con cabello humano y revolucionar el tratamiento de la alopecia. O, al menos, disponer de pelo natural a demanda como modelo de estudio para investigación.
Resuelve las limitaciones del trasplante
«Esto es un sueño para cualquiera de los que nos dedicamos al trasplante capilar», afirma el dermatólogo, Eduardo López-Bran. Aunque es consciente de que aún queda un largo camino hasta la clínica, «se abre la posibilidad de resolver las limitaciones del trasplante autólogo de pelo», dice. Los candidatos que ahora se rechazan podrían tener una opción. Y se pone él mismo como ejemplo: «Un cabello fino como el mío, nunca sobreviviría a un implante. Pero si tengo la posibilidad de hacer crecer un pelo sano y fuerte a partir de mis células, podría ser candidato a trasplante».
Otra ventaja añadida es que permitirá hacer injertos menos agresivos. La técnica sería más sencilla y menos cruenta. «Eliminaríamos el proceso quirúrgico de extracción. Es fácil que en un implante hagamos 6.000 incisiones: 3.000 para extraer el pelo y otras tantas para injertarlas; con esta fórmula nos ahorraríamos la mitad».
Medicina regenerativa
No es la primera vez que la medicina regenerativa obra el 'milagro' de fabricar órganos en el laboratorio a partir de células. Desde que se descubrió que se podía dar marcha atrás en reloj biológico y reprogramar células adultas para convertirlas en cualquier tipo celular del organismo, la lista de 'mini órganos' que crecen en una placa de cultivo no ha dejado de crecer. El resultado no es perfecto, pero está ayudando a entender numerosas enfermedades. A partir de la células adultas, se han fabricado corazones, riñones, pulmones, partes de un intestino y hasta minicerebros. Sin embargo, reproducir una estructura más sencilla, como parece el folículo capilar, no se había logrado aún.

En realidad el folículo piloso es una estructura muy compleja donde nace el pelo. Alojado en la dermis, permite el crecimiento del cabello, gracias entre otras, a la concentración de células madre. En su formación desde el estado embrionario se producen interacciones entre la capa más externa de la piel y el tejido conectivo, un diálogo complejo que no se había descifrado bien. Por eso, hasta ahora no se había logrado reproducir cabello en una placa de cultivo.
Eficacia del cien por cien
La nueva estrategia que siguió el equipo de la Universidad de Yokohama permitió generar folículos pilosos y tallos pilosos con una eficiencia de casi el cien por cien. De su receta, surgieron cabellos de aproximadamente 3 mm de longitud en 23 días de cultivo. Para mejorar su pigmentación se añadió un fármaco para estimular la pigmentación del color del cabello y mejorar su aspecto.
Esta nueva investigación también puede ser relevante en el desarrollo de la medicina regenerativa. No solo para mejorar el crecimiento de otros órganos en el laboratorio sino para contribuir a la comprensión de cómo se desarrollan los procesos fisiológicos y patológicos.
Con células humanas
De cara a futuras investigaciones, el equipo planea optimizar su sistema de cultivo de organoides con células humanas. «Nuestro próximo paso es usar células de origen humano y aplicar este conocimiento en el desarrollo de fármacos y la medicina regenerativa», explica Junji Fukuda, profesor de la Facultad de ingeniería de la Universidad Nacional de Yokohama.
Y más allá de los injertos capilares, su investigación futura podría eventualmente abrir nuevas vías de investigación para el desarrollo de nuevas estrategias de tratamiento para los trastornos de pérdida de cabello, como la alopecia androgénica, que es la más común, tanto en hombres como en mujeres.
Sergio Vañó, director de la Unidad de Tricología del Hospital Ramón y Cajal de Madrid, aplaude el logro del equipo de investigadores japoneses, aunque prefiere optar por la cautela. «Se trata de un buen avance, un paso muy interesante pero aún queda mucho por demostrar y experimentar. Es importante que se sepa que esto no va a llegar en los próximos años».
Alternativas
Mientras tanto, hay opciones. Los tratamientos que luchan contra la caída del pelo están experimentando un nuevo renacimiento. Nuevas y viejas terapias se están reinventando para dar una opción a las personas con alopecia, tal y como se ha debatido esta semana en Bilbao durante la reunión del grupo español de Tricología de la Academia Española de Dermatología en la que también han participado Vañó y López Bran.
Entre las opciones que se han debatido están la toxina botulínica, nuevos fármacos con formulaciones orales más cómodas (minoxidil) o tópicas para eludir efectos secundarios o el uso de hilos tensores y nuevas técnicas de injerto.
Pero entre todas, Vañó destaca la llegada de una familia de medicamentos «que suponen un hito, una verdadera revolución en el tratamiento de la alopecia areata». El baricitinib ayuda a combatir los efectos de esta enfermedad autoinmune en la que las propias defensas del cuerpo humano atacan el cuero cabelludo. Generalmente, se reduce a pequeñas calvas del tamaño de una moneda, aunque a veces se produce una caída total.
Esta funcionalidad es sólo para suscriptores
Suscribete
Esta funcionalidad es sólo para registrados
Iniciar sesiónEsta funcionalidad es sólo para suscriptores
Suscribete